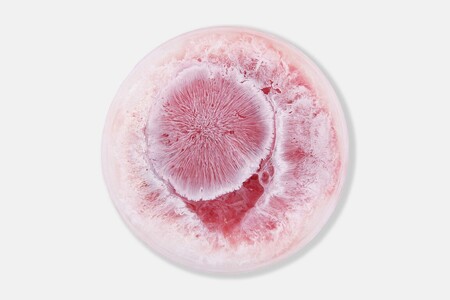

Elementa

В рамках проекта я решила переосмыслить работу с чашками Петри и на этой основе создать магазин химических веществ.
Сначала я попросила ChatGPT придумать название для магазина химических веществ и составить текстовые запросы по референсам для создания основ плакатов.
Полученные изображения


Macro rendering of organic chemical forms in the style of Zaha Hadid: smooth soft-touch texture, pearl white and lavender-lilac gradient, translucency, curves reminiscent of a splash, porous structure.
Логотип
Далее, на основе полученных изображений, я сгенерировала логотип

prompt: Logo with the word «elementa, ” minimalist geometric font with soft curves and large letters, inspired by Swiss modernism and the „form fluid“ poster. White background, black text, balance between a strict grid and smooth organic lines. Clean design, emphasis on letterforms, neat spacing between letters, stylish composition, modern graphics, art direction on par with Bauhaus and Swiss design, vector quality, high resolution. add caption chemical elements laboratory
Плакаты


Add a logo with the number 2 and the words «лаборатория по изучению химических веществ» to 1 image.
Пространство
prompt: futuristic building by the water, designed in an organic architectural style, with smooth biomorphic forms made of white material, large panoramic windows, and soft reflections in calm water, morning fog, delicate pastel colors of the sky, modern minimalism, an atmosphere of silence and the future, architecture in the spirit of Zaha Hadid


In the style of the exterior, create an interior Futuristic laboratory in an organic architectural style, with smooth white and translucent forms, glossy surfaces, soft diffused lighting, an interior with biomorphic curves, a sterile and refined atmosphere, a combination of laboratory equipment and the architecture of the future, inspired by the aesthetics of Zaha Hadid and science fiction design, pastel shades of white, purple, and silver, minimalism, and soft reflections.
Билборды в окружающей среде


Make a horizontal billboard with the image from picture 1 and place it next to the building from picture 2.
Продукты
На основе собственных фотографий из оригинального проекта и изображений, созданных для основы плаката, я попросила сгенерировать чашки Петри
Promt: based on a picture, generate a macro shot of a Petri dish with transparent gel and abstract organic structures inside, soft pink and pearlescent white shades, translucency and fluidity effect, biodesign, a blend of scientific aesthetics and art, realistic lighting, minimalist background, a sense of softness and ephemerality, inspired by biotechnology and contemporary bioart
make a poster-style measuring container
Make glasses with a design from image 1 so that the corners of the bend have elements from image 1, and the background of the image is in the style of image 1.
Использованные нейросети
ChatGPT (создание промптов и повышение разрешения изображений с чашками Петри и билбордов в среде)
REVE (генерации)
Gemini (цветокоррекция пространств)



